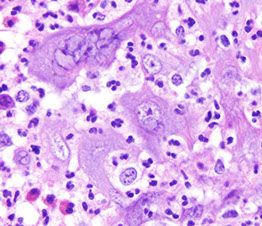

ColoRectum
Colon Histology
Intro to colon biopsy
Appendix histology
Appendicitis
Artifacts
Systemic Disease Findings
Iatrogenic Injury
Gastroschisis
Omphalocele
Hirschsprung Disease
Cystic fibrosis
Irritable bowel syndrome
Reactive changes
Idiopathic Inflammatory Bowel Disease
Ulcerative Colitis
Crohn disease
Angiodysplasia
Intestinal endometriosis
Necrotizing enterocolitis
Diverticulum
Diverticulosis
Diverticulitis
Entamoeba histolytica -see small bowel
Focal active colitis
Lamina propria macrophages
Pouchitis
Cuffits
Eosinophilic colitis
Infectious colitis
Microscopic colitis
- Collagenous Colitis
- Lymphocytic colitis
Ischemic colitis
Intestinal spirochetosis
Nonneoplastic Polyps
- Elastosis / Elastofibromatous change
- Filiform polyps
Mucosal prolapse conditions
- Solitary Rectal Ulcer Syndrome
- Inflammatory Cloacogenic Polyp
- Diverticular Disease Associated Polyps (Polypoid Prolapsing Mucosal Folds)
- Cap Polyposis
- Peutz-Jehgers polyps
- Cronkhite-Canada polyps
Endometriosis
Colonic polyps
- Adenomas
-
- Tubular adenoma
- Tubulovillous and tubular adenomas
- Juvenile polyps
- Hamartomous polyps
- Hyperplastic polyps
- Sessile Serrated polyp
- Serrated polyp / adenoma
- Filiform serrated adenoma
Familial Adenomatous Polyposis (FAP)
- Attenuated FAP (AFAP)
Colorectal cancer
- Colorectal adenocarcinoma
Signet-ring carcinoma of the colon
Colitis-associated Dysplasia and Colon Carcinoma
Carcinoid tumors / NET
Mucious appeniceal neoplasms
Mesenchymal tumors
Hematopoietic tumors
Rectum
Anatomy / Basics
Hemorrhoids
Papillary endothelial hyperplasia (vegetant intravascular hemangioendothelioma)
Infectious Proctitis
Hirschsprung's disease
Irritable bowel syndrome (IBS)
Crohn's disease
Ulcerative Colitis
- Inflammatory polyps
- Pseudopolyps
- Filiform (postinflammatory) polyps
Anal Intraepithelial Neoplasia (AIN)
Anal Squamous Cell carcinoma (ASC)
Paget's disease of the anus
Adenocarcinoma / Anal Gland Carcinoma
Angiokeratoma
Hidradenoma Papilliferum
Mesenchymal tumors
Polyps
Large Bowel (Colon)
Embryology
Develops from all 3 germ cell layers, and rotates around various axes dependent on cell signaling.
Hindgut (SMA) begins at distal transverse rectum, midgut (IMA) begins at ligament of Treitz (??).
Anatomy
Has teniae coli and haustra, visible grossly and microscopically
- teniae coli: concentration of 3 flat bands of longitudinal muscle
-- causes a T-shaped lumen in transverse colon
- haustra: convexities of circular muscle
Posterior portions of the ascending and descending colon, as well as the entire transverse colon, lack a peritoneal lining bc intraperitoneal (important in staging)
- anterior and lateral surfaces of the ascending and descending colon covered c visceral peritoneum (serosa)
- the descending colon becomes the sigmoid colon at the origin of the mesosigmoid, and the sigmoid becomes the rectum at the termination of the sigmoid mesentery
Per CAP protocol, in Total Mesorectal Excision (TME) for tx of colorectal cancer MUST evaluate the Mesorectal Envelope (ME) as A) Incomplete (little bulk to mesorectum; defects in mesorectum extend to muscularis propria, the circumferential margin is very irregular on transverse sectioning), B) Nearly complete (moderate bulk to mesorectum; irregular mesorectal surface with defects >5mm but none extends to muscularis propria; muscularis propria not visible except at insertion points of levator ani muscles, C) Complete (intact bulky mesorectum with a smooth surface, only minor irregularities of mesorectal surface, no surface defects >5mm in depth; after transverse sectioning the circumferential margin appears smooth)
Rectum
- upper 1/3 of rectum covered by peritoneym on front and both sides
- middle 1/3 covered by peritoneum only on anterior surface
- lower 1/3 has no peritoneal covering
Main job is water absorption and electrolyte balance.
- occurs in crypts; regulated by angiotensin and aldosterone
- mucosa largest immune organ in body
-- Mononuclear cells in lamina propria in R > L colon (verify biopsy site before calling IBD)... know where bx is from!!!
Histology
Liquid stool enters through cecum, where H2O absorbed until has harder stool consistency, abundant mucus lubricates its passage
-the right and transverse colon have predominance of absorptive cells, whereas more goblet cells in left colon and rectum
- lamina propria of proximal colon is more cellular c plasma cells, lymphs, and eos than distal colon, and is less cellular in left colon
- Paneth cells seen in cecum and right colon, but not the left colon where their presence can be metaplastic from chronic changes
- lymph aggs are normal, and can be prominent, giving endoscopic impression of a polyp (IELs more prominent over lymph aggs, and should not cause dx of lymphocytic colitis [unless lamina propria is really expanded c inflam and there is epithelial damage])
- macrophages normal and found beneath epithelium
Mucosa, Submucosa, Muscularis Propria, Serosa
Mucosa
Luminal surface covered by glycocalyx
Crypts lined up in parallel like a "test-tube rack," perpendicular to muscularis mucosa.
--in areas w/ test-tube rack not lining up, make sure the muscularis mucosa is there (tethers it down, common false finding)
- innominate grooves: mucosal folds adjacent to lymph follicles that may mimic mucosal injury
Two groups of lymphocytes:
1) CD3/8 +, TCR-aB + suppressor T cells in paracellular spaces of absorptive epithelium
2) CD3/45RO + memory/ CD4RA+ naive T cells and IgM-squirtin B cells in M-cell pockets of lymph
-- Goblet cells scarce next to lymph follicles
5 cell types from multipotent stem cell (found at base, migrate up): 1) Goblet cell, 2) colonocyte, 3) M cell, 4) Paneth cell, and lastly these 5) enteroendocrine cells
Cecal mucosa has > absorptive, < goblet cells, > lamina propria cellularity (inflam. cells) than rectum. Also has (+) Paneth cells.
1) Goblet cells shaped like goblets :) Mucin composition not fixed. Nuclei appear dark, dense, misshapen
- Can highlight mucin w/ PAS, mucicarmine, and Alcian blue
2) Colonocytes (absorptive enterocytes) and M cells decrease and goblet cells increase moving from R to L colon, inferring function.
-- Colonocytes have microvilli lined by glycocalyx; compose majority of surface epithelium
--- cytoplasm lightly eosinophilic, (+) small apical vessels w/ mucin
--- (+) CK8/18/19( increases as cell rises in crypt)/20, pCEA, mCEA, villin, cdx2, AE1/3; (-) CK7, EGFR
3) Membranous (M) cells
In dome region of lymph follicles. Can only make out unique features w/ EM. Immune role (antigen presentation).
4) Paneth cells found in hindgut? Think chronic mucosal damage. Normal in midgut. Look for granular cell at crypt base.
- Triangular, basal nuclei, apical granules (defensins, NOD-2, PLA2, lysozyme, secretory leukocyte inhibitor, FAS ligand, CD15, and TNF-a to name a few.
- Play role in innate immunity
- (+) PAS, phloxine-tartrazine, autofluorescence w/ eosin, HL-5, pancytokeratins (AE1/3)
5) Enteroendocrine cells found mid to deep crypt, in entire colon
- staining can be variable based on function, but also look for chromogranin A, synaptophysin, neuron-specific enolase (NSE), and others (Grimelius???)
-- Muciphages (macrophages that eat mucin) in lamina propria found more distally, b/c that's where > goblet cells, thus > mucin
Apoptosis normal part of gut cell cycle
- look for apoptotic bodies in surface epithelium (less in crypts)
-- pyknotic nuclear debris in cell's basal portion
--- inc. w/ sodium phosphate bowel preps, meds, and dz. (also cause colonocyte flattening, dec goblet cells, surface epithelium detachment, neutrophils in the crypts, RBC extravasation). thus DONT use w/ BM transplant pts.
---- Pseudolipomatosis: looks like fat in tissue, but it's not... just an artifact from blowin air in the colon during colonoscopy.
---- Electrocautery also causes histo changes in specimen (crypt compression and altered nuclei)
Basement membrane: porous to allow cells to pass
- (+) Masson's trichrome, saffron, eosin von Gieson elastin, and autofluorescence w/ eosin (like Paneth cells)
Lamina propria
- lots of inflam. cells. Location of lymph aggregates.
- plasma cell (spitting IgA > other Ig's) predominates, then CD3+ T cells
- inc. eosinophils [(+) CD15] may occur in various dz's, depends on context; can be prominent in the right colon of healthy pts
- mast cells w/ highest density around ileocecal. (+) Giemsa, toluidine blue, tryptase, CD117
- Macrophages usually at crypt base. Can look big, fat, and white if they've been eating a lot of mucin (muciphages). May stain depending on their diet.
-- If lumen distended w/ muciphages, may be due to T. whippelii, M.a.i., histoplasma. Stains w/ PAS, but NOT Alcian blue in these bacterial dz's
Myofibroblasts: Absorption, ion/mucin secretion, immune stuff, stem cell stuff. Two kinds:
1) Pericrypt myofibroblast sheath. Oval/ scaphoid, and overlap. Can be activated or stellate. Attaches crypts together.
2) Subepithelial myofibroblast (SEM) syncytia. Surrounded by fenestrated basal lamina.
Muscularis mucosae
Thin layer of SM; deep limit of lamina propria.
- tethers colonic glands (thus important in eval of structure)
- thickening/ duplication may occur w/ injury/dz
Submucosa
Loose SM bundles, fibroelastic, fat, VAN. May have submucosal lymph aggregate.
-Meissner's plexus just luminal to submucosa (under muscularis mucosa), Henle's deep submucosal plexus on luminal side of muscularis propria.
- Interstitial Cells of Cajal (ICC): moves the gut. Density: myenteric plexus > submucosa.
-- modified myofibroblasts. (+) CD117/34
-- Fusiform body, large oval nucleus
-- Silver stain reveals their connections
Muscularis Externa
-Outer longitudinal, (AUERBACHS PLEXUS!!!) inner circular layers.
Serosa
Flat / cuboidal mesothelial lining + neighboring fibroelastic tissue
Appendix histology
This wormlike (vermiform), 7-10 cm long structure usually comes about 1-3 cm before ileocecal junction at junction of 3 cecal/ ascending colon teniae.
- mesoappendix: appendix mesentery, continuation of the peritoneum which extends length up to tip.
-irrigated by branch of ileocolic a., which lies exposed on outside of appendix and also irrigates mesoappendix. Venous (ileocolic v.), lymph (ileocolic nodes), and nerve (vagus n.[parasymp], sup. mesenteric plexus [symp]) structures go hand in hand with the arterial structure.
Histo similar to that of large bowel.
From lumen out: Mucosa, Submucosa, Muscularis externa, Serosa
Mucosa
Surface epithelium
- Columnar cells: eosinophilic cytoplasm and basally located nucleus. Includes absorptive cells and M cells
- Goblet cells: mucin droplet stains with PAS and Alcian blue. Seen more often in the crypts than in suface epithelium.
- M (Membranous) cells: Columnar, brush border, surround lymph aggregates to help bring in antigens. Can usually find lymphos between them.
--Usually fewer crypts between these M cells and lymph aggregates than in other parts of the appendix
-Crypts spread more unevenly than in colon. Work in cell renewal.
-- Endocrine cells: Flasked- to spindle-shaped. May/not have luminal connection, respectively. (+) chromogranin stain. Found isolated/clustered throughout crypts
-- Paneth cells: abundant eosinophilic supranuclear granules. Found in crypt bases. Function unknown.
- Collagenous subepithelial BM. (+) PAS
-Lamina propria: made of collagen, fibroblasts, VANs, numerous lympho cells. Found in center of mucosa, though can be distorted by lymph aggregates.
-Lymph aggegates: absent at birth, peak in 1st decade then diminish. Similar to Peyer's patches in structure/function. though more cells in appendix have IgG than in colon.
-Mucosal neuroendocrine complex: polygonal cells w/ pale granular cytoplasm beneath crypts. Have neurosecretory cells, neurons, and Schwann cells (thus (+) S-100).
-Muscularis mucosae: continuum from colon, though weaker in appendix, to separate mucosa/submucosa.
Submucosa
Collagenous/ elastic fibers w/ fibroblasts between mucosa and muscularis externa. Also see migratory cells, VANs, Meissner's plexus (ganglion cells, Schwann cells, neurons).
Muscularis externa
Thick double sm. muscle (inner circular, AUERBACH, outer longitudinal) that separates submucosa / serosa. Auerbach's plexus found between 2 sm. musc layers.
Serosa
Nonstratified cuboidal mesothelial cells on top of loose CT of subserosa.
- Attachment of fibrofatty mesoappendix lacks a serosa
Intro to Colon Biopsy
If muscularis propria present on bx, inform endoscopist that there may be a perforation; can also suspect if tissue present from outside GI tract
- scan surface for bugs, and look hard if exudate present, esp for Ameboe
- if pt has diverticula, micro may resemble IBD or mucosal prolapse
- the contents of an expanded lamina propria should be examined closely, mastocytosis may be hard to dx if lots of eos obscure the mast cells; and granulomas can blend in
- chronic colitis requires epithelial inflam, not just inc chronic inflam in the lamina propria (which is normal)
- the dx of "inflam" in bx's are of limited value
Appendicitis
MC surgical emergency in pediatric pts, although can affect all age groups
- appendiceal obstruction MC caused by lymphoid hyperplasia or fecolith
Sx: initial diffuse umbilical pain then becomes localized to RLQ (McBurney's point) 2/2 different internal structures being irritated
- may perforate
(+) Rovsing, Psoas and Obturator signs
DDx: Diverticulitis (elderly); ectopic pregnancy (get B-hCG to r/o)
Dx: clinical, US/CT confirms
Tx: laparoscopic appendectomy on day of dx
Artifacts
Bowel prep using hypertonic enemas (sodium phoshate or Polyethylene Glycol [PEG]) can damage epithelium, causing slight neut inflam, loss of mucin or flat to absent surface epithelium
- sodium phospate (Fleet's enema) preferred by most pts, and can cause small aphthous (spotty) pale mucosal lesions that can look like erosions, and can cause focal FAC or neutro cryptitis, and can inc apoptotic bodies esp at base of crypts (up to 1/10 crypts)
- PEG has fewer artifacts
Gas insufflation can cause bubbles that look like fat, which get called "pseudolipomatosis"
- glands can get squeezed out of their crypts with too much squeeze artifact
Systemic Disease Findings
Scleroderma
GI involvement common in pts c scleroderma, can cause hypomotility and intestinal pseudo-obstruction
- the inner circular muscle is usually affected, so don't see much on bx
Vasculitis
Hard to dx on bx, as inflam in vessel wall can be primary or secondary
- may be able to correlate c other clinical findings to help lead in the right direction
Autoimmune Enteropathy
Colonic mucosal inflam can be abnormal, friable, and erythematous c vascular pattern
- micro can show variety of changes from minimal mixed inflam c little architectural distortion and lamina propria expansion to more vast architectural distoryion c crypt abscesses and goblet cell depletion
- aberrant HLA II has been seen on surface and crypt epithelial cells
Amyloidosis
- similar to rest of GI; tho if found to be localized to gut, without involvement of other organs, can have much better px
- can have variable appearance on endoscopy, such as erythematous patches, nodules, ulcers
Mastocytosis
Mast cells are normally scattered in lamina propria, which can be highlighted c CD117; sx of inc mast cells 2/2 overproduction of histamines
- can be a neoplastic process if too much (systemic mastocytosis)
- clinically and endoscopically may overlap c IBD
- CD25 is specific for mast cells in systemic mastocytosis and is not seen in normal GI mast cells; which can be >100 / hpf
- "mastocytic enterocolitis" is dz c chronic diarrhea c >20 / hpf mast cells, and responds to tx c H1 and H2 antagonists
Langerhans Cell Histiocytosis (LCH)
<5% of pts c LCH have colonic involvement
- micro: lots of macrophages c kidney-bean nuclei in lamina propria in background of T-cells, eos and GCs
- IHC: S100, CD1a
Chronic Granulomatous Disease
disorder in gene responsible for superoxide-making phagocyte NADPH oxidase
- can see poorly formed granulomas
Iatrogenic Injury
Radiation Colitis / Proctitis
Acute phase: hours to days s/p radiation, c edematous, dusky pattern and loss of normal vascular arrangement, c nuclear pyknosis, karyorrhexis, big nuclei and little mits or mucin
Chronic phase: hyalinized CT seen in any bowel layer c atypical fibroblasts, telangiectasia, vessel wall hyalinization, phlebosclerosis and atrophy of muscularis propria, hyalinized vessels may arrange themselves parallel to surface
Mycophenolate (Cellcept) - Associated Injury
Similar to rest of GI, changes similar to GVHD
Ipilimumab is assoc c severe gastroenteritis, may see inc epithelial apoptosis and intraepithelial lymphs
GVHD
Similar to rst of GI, c varying degrees of apoptosis and crypt dropout, can be graded from 1 (inc crypt apoptosis) to 4 (total denudation of mucosa)
Diversion Colitis
Hartmann pouch is a blind-ending distal segment of rectum and / or sigmoid left after a prox segment of bowel resected, that does not have stool passing through it
- in Hartmann procedure, rectosigmoid resected but the colon and rectum not reconnected; instead the prox colon made into colostomy and rectum closed off (rectal stump)
- diversion colitis thought to be def of short-chain fatty acids, which colonocytes need as main source of energy
- colitis usually returns if stool allowed to pass through segment of bowel again
- micro: lots of mucosal lymphoid follicles
- can look like IBD and have crypt abscesses, mucosal architectural distortion, or (rarely) granulomas
Gastroschisis
Typically to the right of the umbilicus
- composed of loops of intestine without covering, essentially an omphalocele that does not have a skin covering and involves all layers of the abdominal wall, from peritonium to skin
- strongly assoc c dec maternal age
- usually an isolated defect
- very high maternal serum AFP
Omphalocele
Closure of abdominal musculature is incomplete and abdominal viscera herniate into a ventral membranous sac
Located in the midline, essentially within the umbilical cord
- composed of multiple viscera, including intestine, liver, and spleen, and it is covered by a membrane composed of peritoneum and amnion
- usually not an isolated defect; assoc c major cardiac defects, chromocomal anomalies (trisomy 21 / 18 / 13) or the Beckwith-Wiedemann syndrome
Tx: can be repaired surgery, most kiddos have other probs
Hirschsprung Disease (HD)
- aka congenital aganglionic megacolon
MCC neonatal constipation (1 in 5000 live births)
- can manifest up to age of school children, 1/10 assoc c Down syndrome, 1/20 assoc c other major neurologic abnormalities
- caused by abnormal migration of neural crest cells to hindgut
- absence of ganglion cells (prematurely die) in distal intestine that lacks both Meissner submucosal plexus and Auerbach myenteric plexus; peristasis absent and causes dilation proximal to the aganglionic segment;
- assoc c axonal hypertrophy
Loss of tonic neural inhibition: persistent contraction of the affected segment, that causes colonic obstruction
Classification: ultrashort segment (<3cm of rectum), short segment (MC, rectum and rectosigmoid affected) or long segment (subtotal colon) or total colonic aganglionosis (colon and part of small intestine)
- there is a normal physiologic zone of hypogangliosis in the rectum, so if squamous mucosa is present on bx, do not make dx of aganglionosis (endoscopist needs to go back to take another bx higher up)
- do not make dx of HD de novo on frozen section
- do not base dx on ACh stain alone, also the ACh-positive pattern is not seen in total colonic aganglionosis
- almost always assoc c some genetic component; heterozygous loss of function mutations in tyrosine kinase RET gene in the majority of familial cases and 15% of sporadic cases
Presents as a failure to pass meconium in immediate postnatal period; obstruction or constipation follows c visible ineffective peristalsis, and can have abd extension and bilious vomiting
- may be difficult to dx if only a couple cm of distal rectum involved
- acquired megacolon can occur at any age from Chagas dz
Dx: relies on H&E, acetylcholinesterase (ACh, produces a Cu-ferrocyanide complex, which identifies abnormal nerve twigs that proliferate into the mucosa in search of absent ganglion cells), calretinin (stains nerve cell bodies in submucosa, myenteric ganglia and lamina propria, and should be absent in HD)
Genes: RET [10q11.2], EDNRB [13q], GDNF [5p]
Cystic fibrosis
MC fatal AR dz in white people in USA
- decreased chloride secretion means that water kept inside cells and mucosa is dry
- can manifest as meconium ileus in inflants (dry, compact meconium in the TI), but meconium ileus can occur in other dz's
Irritable bowel syndrome (IBS)
Prevalence of up to 1/5 in US, sx include abd discomfort, bloating/distention, change in stool freq / consistency
- endoscopy should be done in pts > 50 yo c IBS, or c sx that can be caused by other dz
- may classify pts as constipation- or diarrhea-predominant
-- excess bile salt flow can cause changes in intestinal mobility
- other causes may be from abnormal brain-gut signaling; hormonal or immunologic imbalance, s/p infx, atypical gut microbiota
- most bx's eval'd for chronic diarrhea are normal
- px: the longer the sx last, the less chance there is of improvement
Reactive changes
Signet Cell Change
Usually seen c pseudomembranous colitis, where sloughing cells can get lots of intracytoplasmic mucin, and can look a little nastry from reactive changes in general
Atypical Stromal Cells
Vimentin-only-+ fibroblasts that can be seen anywhere in GI, can look like pleomorphic sarcomas but dont form a mass and are located in polyps / ulcers or in a single layer of cells
- can have atypical mits
Inflammatory Bowel Disease (IBD)
Includes chronic UC and Crohn dz, which can have overlapping features bwt them and with other inflam dzs
- incidence of UC slightly higher than Crohn disease
- inappropriate immune activation in both cases
- IL-23 receptor and Th17 cells involved in pathogenesis
- making abs against bacterial flagellar protein flagellin assoc c NOD2 variants in Crohn dz (uncommon in UC)
- fecal transplants may benefit IBD pts
Ulcerative Colitis (UC)
Autoimmune dz c chronic destructiion of crypts presenting c periodic bloody diarrhea and no abdominal mass, MC in ~20 yo
- primarily based in mucosa c continuous rectal involvement affecting only superficial layers (mucosa and submucosa)
- pseudopolyps (appear so 2/2 loss of surrounding mucosa) freely hanging on mesentary, also see filiform (post-inflammatory) polyps at any stage; also inflammatory polys (seen when mound of normal mucosa in pseudopolyp protrudes and surrounding degenerated epithelium regenerates)
- endoscopically varies c degree of activity depending on several factors (tx, duration, severity), involving rectum and moving prox, making mucosa look bloody red that is friable and granular
- normal sub-mucosal vasculature lost, to endoscopist this is a clue for chronic colitis
- pt may lose haustral folds from repeat inflam
- generally confluent, but can have "skip" areas in cecum
- diffuse chronic duodenitis assoc c UC is predictor of pouchitis
- should start screening for cancer 8-10 yrs after dx of UC, in which multiple bx's are taken
Imaging: "Lead-pipe" appearance
Micro: architectural distortions (from repair) and inc chronic inflam (eos, lymphs, plasma cells)in mucosa characteristic; crypt abscesses (neuts in crypt lumen) and cryptitis (neuts in crypt epithelium), ulcers, bleeding, no granuloma formation
- regenerating glands don't have mucin or mature goblet cells and are immature
- lymph aggs seen at mucosal - submucosal interface
- although granulomas not common, can have granulomatous foreign body response (which is a granuloma, but causes confusion in reports) or mucin granulomas
- commonly see Paneth metaplasia, but not as much pyloric metaplasia
- usually not too much inflam in submucosa, and not transmural
-basal plasmacytosis seen in UC and Crohn
Complicated by toxic megacolon, colorectal ca (up to 10%), malnutrition, arthritis, uveitis
Extraintestinally can see pyoderma gangrenosum and primary sclerosing cholangitis (PSC) or Primary Biliary Cirrhosis (PBC)
Dx: (+) p-ANCA (70%), no specific tests avail
- should initially r/o bugs (shig, Salm, C jejuni, CMV etc)
- has Th2-like inflammation
DDx: Crohn dz (usually correlates c ASCA, not p-ANCA), long-standing infx (has more acute inflam in lamina propria, and less architectural distortion), medications (NSAIDS), chronic ischemic colitis (differentiate c pt age, location of inflam, inc muscularis propria inflam, and lack of acute inflam in epithelium)
Tx: 5-ASA preparations [sulfasalazine], steroid enema in acute dz; infliximab, colectomy
- azathioprine and 6-MP used to wean pts off roids
Px: If fatal, occurs in first 2 yrs of dz, and 2/2 fulminant dz (toxic colitis)
- long-standing inflam assoc c dysplasia and adenocarcinoma (need annual biopsies if have dz >8 yrs) which is usually left-sided, ulcerated or flat, and well to mod differentiated
Crohn disease
- aka regional enteritis, granulomatous enterocolitis, terminal ileitis
Chronic, relapsing and remitting c skip lesions affecting multiple portions of the GI tract from mouth to anus (though rectum usually spared), M=F, peaks in 3rd decade; whites > other races
- Jews> non-Jews
- despite skip lesions, will see deep, transmural inflammation c cobblestone mucosa, creeping fat, fissures, fistulas (goes all the way through the wall!) causing the wall to be thick (vs thin in UC)
- can have cramping pain in RLQ (mimics acute appendicitis), have abdominal mass and non-bloody diarrhea, weight loss and Fe-def anemia (mimics celiac dz)
- grossly see apthous erosions, longitudinal (tram track) ukcers, and adjacent areas unaffected; also cobblestoning
- rectum usually spared and ileum affected (vs UC)
- can get cutaneous granuloma, called metastatic Crohn disease
- fibrosing strictures common, and require excision
- extraintestinal manifestations: uveitis, migratory polyarthritis, sacroileitis, ankylosing spondylitis, erythema nodosum, finger clubbing, pericholangitis, PSC
- Th1 cells polarized, Th17 cells as well as IL-23 receptor polymorphisms
Micro: noncaseating granulomas (seen in ~1/2 of surgical cases; though not specific [also seen in some immune conditions {CGD}]) and lymph aggs, crypt abscesses, architectural distortion, Paneth cell metaplasia in left colon where you dont usually see Paneth cells,
- lymph aggs seen as "sting of pearls"
- some areas may be completely normal
- regions of pyloric metaplasia indicate inflam and repair
- basal plasmacytosis seen in UC and Crohn
- May appear similar to reaction to mycobacteria, possibly bc genes involved in mycobacteria infx same as those in Crohn (NOD2, IRGM)
Complicated by fissures and fistulas
- fissures occur bwt bowel loops and other hollow organs, or can just perforate into abdominal cavity
Labs: Anti Saccharomyces cervisiae antibody (ASCA) (+) and ANCA negative (vs UC)
- has Th1 inflammation
Genetics: (Caspase Recruitment Domain) CARD and NOD2 protein which is signal transducer for inflammatory cells which are activated by bacterial products
Dx: need to r/o malignancy c bx
DDx: infx colitis, rx-colitis, UC
Tx: roids (for acute flares), infliximab, metronidazole may prevent
- screening: after 8-10 years of colonic involvement scope em every 1-2 years
Px: Inc risk of colon ca (which is mucinous and usually poorly-diff)
Indeterminate Colitis
For pts that have too much of overlap bwt Crohn and UC; dx'd in 1/10 IBD pts
- look for possible inciting features in the pt hx
Colitis-associated Neoplasia
A possible complication of UC or colonic Crohn dz
- depends on the duration and extent of dz, and the severity of inflam response
- pts should get scoped 8 yrs after dx of IBD
- dysplasia can develop in flat areas of mucosa
- HG dysplasia may raise fear of ca in other place in colon, and usually leads to colectomy
- LG dysplasia can get colectomy or can be closely fu'd
Angiodysplasia
- aka telangiectasia or varicose veins of the GI tract
Accounts for 20% of all major lower GI bleeds
- MC in cecum, but also in terminal ileum and ascending colon
-- MC in cecum due to the law of LaPlace: cecum has the largest diameter and therefore the largest wall tension [?]
Risk factors: ESRD, von Willebrand's dz, aortic stenosis, older age [?]
Gross: Tortuous vessel dilation which causes bleeding
- GI repeatedly expands and contracts, vessels penetrate submucosa, some get occluded which leads to focal dilation
Dx: Angiogram
Tx: cauterization
Intestinal endometriosis
MC in RS colon, appendix and sm intestine, can mimic other conditions (cancer, appendicitis) and seen in up to 2/5 of female pts c endometriosis
IHC: stromal component is CD10 (+); glandular and stromal components are ER/PR (+)
Necrotizing enterocolitis
Necrosis of intestinal mucosa c possible perforation that usually involves colon but can involve entire GI tract
- has non-specific systemic signs (rectal bleeding) and abd sx
- MC in neonates
Grossly can see pneumatosis intestinalis (gas in the wall of the intestine)
- may form pseudomembrane
Dx: Clinical
Diverticulum
Blind pouch that protrudes from gut lumen
Is "true" if involves all 3 gut wall layers (aka Meckel's) in its outpouching
- most are "false" or "pseudo" pouches that have only a couple of the layers outpouched
MC in sigmoid colon
- caused by weakness created where vessels (vasa recta) penetrate the muscularis externa
Diverticulosis
Common ailment affecting half ppl > 60 yo in which many diverticulae are present
- assoc c low-fiber diet; are right sided in rest of world, left-sided in USA, probably from diet
Often asymptomatic
Micro: hypertrophy of the circular layer of muscularis propria common
Dx: Barium enema [???]
Diverticulitis
- acute inflam of diverticulum of deverticulosis
Sx: "Left-sided appendicitis" --> LLQ pain, fever, leukocytosis, BRBPR
- pneumaturia: can piss air if forms a fistula c bladder
Dx: CT c PO + IV contrast
- do NOT do colonoscopy or barium enema bc risk of perforating diverticulae
Micro: can mimic IBD, c crypt distortion, lamina propria expansion c lymphs and plasma cells
Tx: Ciprofloxacin and metronidazole
Px: 1/3 will have recurrence in few years
Focal active colitis (FAC)
Single or multiple foci of neuts in colon crypts
- though this may raise suspicion for Crohn dz, no real connection bwt them
- 1/5 may have C jejuni infx
Lamina propria macrophages
Highlighted by CD68 these are a normal part of the lamina propria, where they are involved in phagocytosis and ag-presentation
- called muciphages if they've eaten lots of mucus (common finding)
- melanosis coli is the presence of lipofuscin in pigmented macrophages (very common, esp in older pts), assoc c laxative use or anthraquinones in general (found in aloe vera)
Lipid-laden macrophages can give a "chicken-skin" appearance, probably 2/2 local injury
Pouchitis
Inflammation of a pouch created after bowel removal, as in Koch (K-) pouch, or Ileal Pouch Anal Anastamosis (IPAA)
- inflam of blind pouches (eg Hartmann pouch) called diversion colitis
- hard to tell if inflam is from abn anatomy or inflam dz recurrence
- may be assoc c backwash ileitis and diffuse chronic duodenitis
- if pt has dx of "indeterminate colitis" before resection, have double the chance of getting pouchitis than pt c UC
- some pts get Crohn-like dz in continent pouch, requiring revision
Micro: acute inflam in acute and chronic inflam c villous atrophy in chronic, possibly mimicking Crohn or UC
- not necessary, but may classify as A (pretty normal), B (mild atrophy, mod inflam), and C (servere atrophy and inflam)
- histo features can be indistinguishable from Crohn dz
Tx: Metro / abx
Cuffits
Rectal cuff usually left when pouch created, and still has dz
- low risk of transformation to neoplasm, but can still be bx'd
Eosinophilic colitis
No clear diagnostic criteria
- normal finding in rt colon, amt depends on pt geographic residence and season of year (up to 4 eos / 4 hpfs in epithelium and 45 / 4 hpfs in lamina propria); and also seen in left colon (generally absent in epithelium but up to 22 / 4 hpfs in lamina propria)
- should tell clinician to correlate c CBC and allergix / infx sx if inc eos are really seen
- can be seen in lots of conditions, not really a specific finding
Infectious colitis
- see Microbe Parade!, sm bowel
Bacterial infx (usually Campylobacter or Aeromonas) can cause self-limited acute colitis; vs ischemic pattern of colitis seen c EHEC
- lacks the basal plasmacytosis seen in UC and Crohn and glandular architecture is preserved
- can correlate c stool sample results / cultures
- HIV pts can have giant cell colitis
- may see Strongyloides, CMV, spriochetes (Brachyspira, may be seen in up to 1% of pts c chronic watery diarrhea)
- necrotizing epithelioid granulomas can be seen c Yersinia pseudotuberculosis, and macrophage aggregates c Yersinia enterocolitica
- histoplasma can mimic IBD, also Blastocystis and Entamoeba
- amoebas can be found in ulcer-assoc exudates
- Michaelis-Guttman bodies (usually in urinary tract) can be seen when macrophages ingest degenerating bacteria)
- can get STDs in MSM or AIDS pts
- worms usually seen on endoscopy
Microscopic Colitis
- term used when pt has chronic watery diarrhea, but normal endoscopic findings, and there are microscopic abnormalities
- can refer to collagenous colitis or lymphocytic colitis, which both have inflamed lamina propria and surface injury
Collagenous Colitis
Older women c chronic diarrhea; right and transverse colon > left
- assoc c NSAIDS and Celiac dz
Sx: High vol watery diarrhea but with normal endoscopy, also abd pain, weight loss and fatigue
- may see linear mucosal tears on endoscopy, esp assoc c PPI's
Micro: thick subepithelial collagen that looks basket-weaved, but it is the fact that the deposition of collagen creates an abnormal lower border (instead of a well-defined lower border) that exapnds out and entraps nuclei that really defines collagenous colitis, and not the thickness / quantity
- also see signs of epithelial injury (nuclear irregularity, loss of mucin, epithelial injury, intraep lymphs) but normal crypt architecture, can have slightly inc eos and neuts (though too many neuts suggests superimposed infx colitis)
- surface epithelium stripped (breaks off) from thickened collagen layer
- may be on the same spectrum as lymphocytic colitis,
Tx: immunosuppression
Lymphocytic Colitis
M=F, pts in 70-80s, but can also affect all ages and assoc c NSAIDs
Sx: also chronic watery diarrhea c normal endoscopy
Micro: loss of mucin, epithelial injury, intraep lymphs (similar to collagenous colitis), but lacking the thick subepithelial collagen layer, and does not have neuts
- it is not just the presence of surface lymphs that define this disorder (as they may be present in infx / rx), must be in the correct clinical setting
Ischemic Colitis
Can affect just mucosa, mural (from hypoperfusion), or transmural (if major vessel messed up)
- watershed areas most vulvernable to ischemia; usually develops from atherosclerotic narrowing in splanchnic circulation
- usually in older pts, but can also be seen in neonates (multiple etiologies)
- E coli O157:H7 and C diff known to produce ischemic presentation
- assoc meds: illegal drugs (cocaine), NSAIDS, OTC decongestants, OCPs, Kayexalate, sumatriptan, alosetron
Can see ulceration, hemorrhage, thinning, gangrene - must carefully dissect blood vessels leading up to ischemic areas when grossing!! (lets you see the vascular lesions)
- may form pseudomembrane
Micro: Marked surface injury, mucin loss in crypts, atrophic microcrypts, lamina propria hyalinization (lamina propria collapses c red stuff filling in), necrotizing phlebitis, thrombi formation
- necrosis, ulceration, granulation tissue extend into submucosa and surrounding smooth muscle
- can have atypical mits and cellular atypia
- usually not too much inflam, can see crypt abscesses









Normal appendix



Pseudolipomatosis from gas insufflation

Intestinal mastocytosis

Radiation colitis
Radiation colitis



Gastroschisis


Omphalocele

Hirschsprung disease. A) preoperative barium enema showing constricted rectum and dilated sigmoid colon. B) corresponding intraoperative photo showing constricted rectum and dilation of the sigmoid colon


Acetylcholinesterase (Ache)


ACHe finds cholinergic nerve twigs that prolif in mucosa in search of absent ganglion cells
Calretinin


Calretinin normally stains nerve twigs in muscularis mucosae and lamina propria, which are absent in HD


Benign signet ring cells in pseudomembranous colitis




Colonic pseudopolyps in pt c intractable ulcerative colitis

Pts c UC can sometimes have aphthous ulcers in the oropharynx

Crypt abscesses are classic findings in pts c UC

Marked lymphocytic infiltration of mucosa




Microscopic pathology of Crohn disease. A, Haphazard crypt organization results from repeated injury and regeneration. B, Noncasearing granuloma. C, Transmural Crohn disease with submucosal and serosal granulomas (arrows)

Microscopically, Crohn disease is characterized by transmural inflammation. Here, inflammatory cells (the bluish infiltrates) extend from mucosa through submucosa and muscularis and appear as nodular infiltrates on the serosal surface adjacent to fat. Note the granulomatous inflammation.
Angiodysplasia of colon




Endometriosis in colon


Eosinophilic colitis



Amebic colitis, Entamoeba histolyica
Collagenous colitis

Collagenous colitis trichrome

Lymphocytic colitis

Small bowel - ischemia

Elastosis / Elastofibromatous change
Inc focal or diffuse elastic fibers in submucosa or muscularis mucosa, which manifests as a polyp
- B9, no clinical action needed
Micro: looks like finely granular c fibrillary amphophilic material, sometimes elastofibromatous change (fibrous component), usually around BVs and sometimes mistaken as amyloid (elastin pos, Congo red neg)
Filiform polyps
aka post inflammatory polyps
- assoc c prior mucosal injury; common in pts c IBD
- grossly can simulate a neoplasm
Micro: projections of submucosa covered by mucosa
- their form is 2/2 regrowth of mucosa of area of ulcer damaging the submucosa
Mucosal prolapse conditions
Can occur to some of the diseases listed below, or can be physiologic, as is sometimes seen at the ileocecal valve
Solitary Rectal Ulcer Syndrome
Pattern of polyps lacking ulceration localized to terminal rectum assoc c mucosal prolapse, usually Left side (?)
- classic hx is young woman straining when poopin; possibly c hematochezia, pain, tenesmus, lower abd pain (possibly 2/2 lack of coordination in the poopin muscles)
- some pts can have ulcers, or can have masses
- endoscopist should sample any ulceration around prolapse to exclude ca, which can present in similar fashion
Micro: muscularis mucosa hypertrophy, splayed fibers going to lamina propria and mucosa
- glands trapped and distorted (diamond-shaped) 2/2 fibrosis
-- can have serrated features, leading to confusion c SSA
- glands herniate to submucosa with surface ulceration
- thus broken down into polypoid- and ulcerated stages
Inflammatory Cloacogenic Polyp
Has both squamous and columnar epithelium, as arises from anterior portion of transitional zone presenting c prolapse which can cause hematochezia
Micro: tubulovillous c ulceration, crypts penetrate to submucosa, lots of fibromuscular straoma into mucosa
Diverticular Disease Associated Polyps (Polypoid Prolapsing Mucosal Folds [PPMUFs])
Pulsion diverticulum - mucosa and muscularis mucosa penetrates through mscularis propria
- Smooth muscle prolif around diverticulum, causing folding of mucosa, which can be inflamed
- folds can prolapse, forming polyps (bx of the polyp can cause bowel perf [finding muscularis propria warrants call to endoscopist])
- smooth muscle herniates into mucosa (muscularis mucosa into lamina propria), the mucosa into the submucosa, ; also reparative epithelium seen
- crypt dilation and distortion
Cap Polyposis
Rare, b9, lots of polyps (sometimes >100) in distal rectosigmoid c inflammatory cap of granulation tissue c normal mucosa
- F>M, all ages but esp 6th decade, present c bleeding, mucus in diarrhea, can lose lots of protein
Tx: may need colectomy if severe, otherwise immunomodulation, possibly H pylori tx and avoiding straining
Peutz-Jehgers polyps
Similar manifestation as in other sites
mucosa divided by cords of sm muscle running through groups of glands
Cronkhite-Canada polyps
Diffuse polyposis in pts c unusual ectodermal abnormalities, suvh as alopecia, onychodystrophy, and skin hyperpigmentation
- inc risk of colorectal ca possibly; more at risk of prolapse, bleeding and intussusception
- polyps spare the esophagus
Micro: broad-based sessile polyp c expanded lamina propria and cystic glands
- flat mucosa is abnormal bwt glands (vs normal in JP)
Px: polyps are almost never dysplastic
Endometriosis (EM)
Seen in 2/5 pts c EM, MC in sigmoid colon
- may also see deciduosis (ectopic decidua) in pregs
- appears same as in other sites
- can mimic Kaposi sarcoma
Elastofibromatous change mimicking amyloid



Nice long filiform polyps from the colon of a Crohn's patient
Solitary Rectal Ulcer Syndrome
Haphazardly arranged benign colonic crypts



Inflammatory Cloacogenic Polyps


Mucosal prolapse polyps. A, Inflammatory (cloacogenic) polyp of the anorectal transition zone. B, Strands of thickened and splayed muscularis mucosae extend around the crypt bases and into the overlying lamina propria. The crypts assume an angulated and distorted appearance. C, When embedded tangentially, prolapse polyps show strands of smooth muscle that appear to encircle colonic crypts, which frequently assume a “diamond” shape. D, On the surface, mucosal prolapse polyps often contain markedly regenerative, serrated/hyperplastic-appearing epithelium and ischemic-type changes with erosion. [2]
Cap polyposis


nflammatory cap polyp. This type of inflammatory pseudopolyp shows an overlying “cap” of necroinflammatory exudate. These polyps may occur in the setting of cap polyposis, at anastomotic sites, in association with inflammatory bowel disease (as in this case), or in many other conditions that induce mucosal ulceration. [2]
Colonic polyps
-90% benign, though chance of malignancy increases with size, dysplasia, and villous histology
- adenomas left in situ have ~4% chance of malignancy; but only invasive ca has potential for mets; chance of malig inc c size (polyps >2 cm should be removed intact if possible to eval margins)
Tumors at risk for recurrence or residual dz include HG-tumors that are poorly diff, signet ring, small cell or undifferentiated; also tumors that are <1 mm from resection margin, or involvement into thin-walled (possibly lymphatic) vessels
- any of the above features require further tx
Suspected order of increasing malignant potential:
1. Hyperplastic polyp: MC non-neoplastic polyp in colon
- >50% are rectosigmoid; no malignant potential (not really an adenoma...)
2. Tubular adenoma
3. Tubulovillous adenoma
4. Villous adenoma (the VILLAIN!)
- should remove adenomatous polyps b/c precancerous
Cowden syndrome: AD hamartomatous poly syndrome assoc. w/PTEN mutation
- loss of PTEN --> unregulated cell growth: intestinal hamartomatous polyps, macrocephaly, benign skin tumors + hemangiomas/lipomas. No inc. risk of GI malignancy, BUT there IS inc risk of breast, thyroid, and endometrial ca. risk.
Hyperplastic polyps: MCC benign polyp
Adenoma
Dysplastic by definition, can be difficult to distinguish dysplasia from inflam; MC neoplastic polyps
- see lots of em in FAP
- initiation pt of adenoma is near mucosal surface, and grow in top-down manner, spreading into the crypts
Micro: elongated "pencil" hyperchromatic nuclei
- can see apoptotic bodies or clear-cell change, or squamous morules (similar to those in endometrium)
- larger villi can undergo crypt separation that may be reminiscent of a TV adenoma, but TV adenomas have long, well-formed finger-like villi
- can undergo striking gland prolapse, with glands in the submucosa which can look worrisome for invasive ca (called "pseudoinvasion"), except this usually take muscularis mucosa with it and the glands are more rounded and assoc c hemosiderin
No well-est criteria for HG-dysplasia, though size and probability of HG dysplasia are directly correlated
- if adenoma harbors carcinoma and invades lamina propria (Tis), still is equivalent as HG-dysplasia and polypectomy is curative
Tubular adenoma
asdf
Px: pts c 3+ adenomas, HG dysplasia, adenoma >1 cm or villous features need more intense FU
Colorectal polyposis syndromes

Tubulovillous (TVA) and Tubular adenoma
Not sure when to differentiate the 2
- no real consensus on what "villous" features are
- can probably just lump the 2 together and dx TVA when villi are well-formed
Juvenile polyps
- aka Retention polyp (if solitary lesion?)
Sporadic, usually solitary in kiddos <5 yo. 80% in rectum.
- Not malignant if single; not usually assoc c juvenile polyposis syndrome
- MCC rectal bleeding in children; and may cause intussusception
- MC pediatric polyp (9/10)
Juvenile polyposis coli (JPC) syndrome: AD, Inc risk of adeno CA in mid 30's 2/2 many juvenile polyps in GI, present c rectal bleed (19/20), polyp prolapse, diarrhea, protein-losing enteropathy, failure to thrive, intussusception, also assoc c craniofacial anomalies, cardiac anomalies, cryptorchidism, and mental retardation
- usually found in colon (as in juvenile polyposis coli) but can be found in stomach and small intestine
- May do prophylactic colectomy.
- considered hamartomatous, so so in colon they have irregular, dilated glands c edema and granulation tissue in the lamina propria
- Juvenile polyposis must have: JPs thoughout GI, >5 JPs in colorectum, family hx of JPs
- can be small and subtle or large
- assoc c juvenile polypsis, Cowden syndrome, Bannayan-Riley-Ruvalcaba syndrome
Micro: Disorganized crypts, dilated glands filled c neutros and mucin c edematous lamina propria
spherical lobulated surface, usually eroded
- may be hard to differentiate from an adenoma
- mucosa bwt JPs is normal and not inflamed
Genes: DPC4 (SMAD4) / BMPR1A gene (usually point) mutations in 60% on 18q21
- involved in BMP/TBF-B pathways
- both genes involved in TGF-B superfamily signaling pathways
- crypt:stroma ratio may be dependent on type of genetic defect (>1 in SMAD4 mutations; <1 in BMPR1A muts)
Px: up to 3/4 pts get colon ca by age 60 years if syndromic
- no inc risk of cancer in solitary polyps
Peutz-Jeghers: Again, no malignancy in single polyps.
Puetz-Jeghers syndrome: AD, many non-malig. hamartomas (mucocutaneous melanin deposits) throughout GI. Also see: hyperpigmented spots in mouth, hands, lips, and genitals. Inc risk of colorectal CA and other visceral malig (colon, breast, lung, ovaries)
-buccal lesions persist
- 50% hace cancer in 6th decade of life

Juvenile polyposis coli. The resected colon harbors numerous sessile and pedunculated, reddish polyps. These polyps are less numerous than those seen in familial adenomatous polyposis and are characteristically grouped in the region of the rectosigmoid. (Courtesy of Emma E. Furth, MD, University of Pennsylvania, Philadelphia, PA.) [2]

Classic juvenile polyps. A, These polyps grossly appear rounded, smooth, and unilobular with an erythematous cap of eroded tissue. (A, Courtesy of Thomas C. Smyrk, MD, Mayo Clinic, Rochester, MN.) B, Their cut surface reveals multiple dilated, mucin-filled crypts, leading to the term mucus retention polyp. C, At higher power, the crypts are dilated and branched. Some, like the one at center, contain crypt abscesses, collections of neutrophils, or eosinophils. The surrounding stroma is also expanded and contains numerous mixed inflammatory cells. [2]

Hamartomous polyps
- aka Peutz-Jeghers polyp
Clonal overgrowth of native stem cells, may have any of the 3 germ cell layers, AD inheritance, MC in small intestine, 1/4 in colon or stomach
- assoc c SCTAT, bowel adenoca, adenoma malignum cervix, mucinous tumors of ovary, uterus, breast ca, lung and the pancreas
Histo: sm muscle tree-pattern
Genes: STK11 in Peutz-Jeghers syndrome
- SMAD4 / BMPR1 genes involved in juvenile polyposis
Px: may be considered pre-neoplastic in some cases

Hamartomatous polyp c sm muscle


Hyperplastic Polyp (HP)
MC serrated polyp (3/4) multiple, inc c age (3/4 people have it over age 40 yr); may result from dec epithelial cell turnover and delayed shedding of surface epithelial cells, causing a pile up of goblet cells and absorptive cells; main significance is that they must be distinguished from SSA
Sessile polyp <1 cm, usually left colon (should reconsider dx if on right side [?], probably a SSA)
- can be microvesicular, goblet cell rich, and mucin-poor (no clinical significance in differentiating)
- multiple polyps should be called "serrated polyposis" and not "hyperplastic polyposis" (have >20 serrated polyps throughout colon, at least 5 prox to sigmoid colon 2 of which >1 cm, or if FamHx)
long dilated crypts, serration in the upper crypt or micropapillation, thick BM, regnerative epithelial change, prominent NE cells at base
Px: no inc ca risk (10-yr FU interval)
- HPs > 1 cm usually require closer f/u

MUTYH assoc polyposis (MAP)
Sessile serrated adenoma (SSA)



Sessile Serrated Adenoma (SSA)
- aka sessile serrated polyp
Right colon (rare on left), broad-based, M=F, large, mucus cap and poor definition on endoscopy, have serrated architecture throughout the full length of the gland
- 1/10 colon polyps, up to 1/4 serrated polyps
- inc in pts c MSI-H
>1 cm ca risk
To dx need one of these:
- 5+ proximal to sigmoid bowel, 2 must be >1cm
- any number of serrated polyps in pt c relative that has serrated polyps
- >20 serrrated polyps
3 types (type 1 assoc c ca):
Type I: large (>1 cm)
Type II: lots of em (>20), do not have SSP morphology and ca asoc doubtful
Type III: MUTYH-assoc polyposis (MAP)
- AR pattern, has KRAS mutation but lacks CIMP and BRAF
- usually see 10-100 polyps (less than FAP); ~2/3 are right-sided
- is the only known recessive hereditary ca syndrome
- MUTYH is part of the DNA base excision repair system that protects genomic info from oxidative damage
-
Micro: basal crypt dilation, crypt branching, serration to deep crypts, papillary invaginations, inc epithelil:stroma ratio, lack surface BM, NE cells rare at base
- abnormal prolif / dysmaturation - persistent nuclear atypia high in crypts and high mits
Hyperplastic (Serrated) Polyposis - loss of hMLH1
- MSS, MSI-l/-H ca's
Genes: Activating mutations of BRAF gene (BRAF V600E mutation) cause epithelial cells to overgrow in BM, causing serration
- some c Microsatellite Instability (MSI)
- loss of MLH1 occurs c dysplasia
Serrated polyp of the appendix differs from sessile serrated polyp / adenoma of the colon bc it favors KRAS mutation over BRAF mutation
Tx: excise
- if large and taken out in several chunks go back and scope in 3-6 mo's to make sure everything was taken out
- any proximal serrated lesion >1cm is a SSP, regardless of histo
- Rescoping guidelines: <1 cm = 5 yr FU, >1 cm = 3 yrs, if has dysplasia or serrated polyposis syndrome= every year, traditional serrated adenoma = 3 yrs
- Cetuximab, panitumumab (monoclonal abs), Gefitinib, erlotinib(LMW TKIs)
Traditional Serrated Adenoma (TSA)
- aka serrated adenoma
Left or distal colon, pedunculated
Majority are rectosigmoid
- similar ca risk as adenomas
Micro: complex villous architecture c crypts that lose orientation to muscularis mucosa (aka ectopic crypt formation [ECF])
Hyperplastic architecture + adenoma changes
(+) KRAS mutations and CpG island methylation and are beleived to be cancer precursors; although they lack MSI
Filiform Serrated Adenoma
Left-side c long filiform projections lined c serrated epithelium, edematous stroma and columnar cells c abundant red cytoplasm
- can have BRAF or KRAS mutations
Traditional Serrated Adenoma (TSA)





Familial Adenomatous Polyposis (FAP)
AD mutation of Adenomatous Polyposis Coli (APC) gene (assoc c D-cadherin/ B-catenin) on cr 5q21 is tumor suppressor gene that suppresses Wnt signaling
- dec APC --> inc B-catenin in nucleus --> uncontrolled transcript activation
- the MC (up to 9/10) mutation in APC are nonsense/frameshift mutations causing premature stop codons
See thousands of polyps throughout the colon and rectum
- 100% progress to CRC
Screening in pt c FAP is done every year starting at 12 yo
- may do protein truncation assay, or SSCP, or gene sequencing
When to test?
- >10 colorectal adenomas
- FamHx of adenomatous polyposis syndrom (FAP, AFAP, MAP)
- Hx of adenoa + FAP-xtracolonic manifestation
Test for APC (Adenomatous Polyposis Coli), MUTYH, PPAP
Tx: prophylactic colectomy
Px: death from CRC
Attenuated FAP (AFAP)
- has less than 100 polyps and risk of ca is increased (~3/4) but not as much as full-blown FAP
Algorithm for eval of suspected MSI (if has mucinous or medullary features, TILs, Crohn-like rxn, or pushing margin


AJCC 7th ed colorectal ca staging

Colorectal cancer
3rd MCC cancer; 2nd or 3rd most deadly cancer in US; >90% adenoca
- in 2020, 147,950 new cases, 53,200 deaths
- most pts >50 yo; 25% c + FmHx
- at 50 yo start screening c FOBT, fecal DNA test, and/or sigmoid colonoscopy every 5 yrs, colonoscopy every 10 yrs, CT colonography every 5 yrs or double-contrast barium enema every 5 yrs
Sx: Distal colon: obstruction, chronic colicky pain, hematochezia
Prox colon: dull pain, Fe-def anemia, fatigue
**** left obstructs, right bleeds ***
Risk factors: IBD, S bovis, tobacco, large villous adenoma, juvenile polyposis syndrome
- ALL metastatic CRCs should undergo molecular profiling [3]
- ALL CRC tumors should be tested for Mismatch Repair Deficiency (MMR-D) via IHC or Microsatellite instability-high (MSI-H) via PCR to test for Lynch syndrome [3]
-- prevalence of Lynch syndrome is 0.3% in general population, with 3% of CRC occurring in people with Lynch syndrome
Genetics: Familial Adenomatous Polyposis (FAP), Hereditary NonPolyposis Colorectal Cancer (HNPCC; aka Lynch syndrome);
HNPCC has germline mutation in mismatch repair genes (usually MLH1 and MSH2, but in a few see MSH6 and PMS2)
Nuclear DNA mismatch repair (MMR) genes: MLH1, MSH2, MSH6, PMS2 and EPCAM
- microsatellite instability either through promoter hypermethylation (silences gene expression, seen in sporadic colorectal ca [1/3 colorectal ca's]) or by germline mutation (as in Lynch sundrome / HNPCC [3% of colorectal ca's]) - 95% sens, 100% spec
-- if all (+), then no defective MMR by IHC; if MLH1/PMS2 neg then MLH1 is defective (9/10 sporadic loss [promoter hypermethylation] 1/10 germline mutation); if PMS2 neg, then probably PMS2 germline mutation; if MSH2 and MSH6 neg, then defective (germline mtation) MSH2; if only MSH6 neg then germline MSH6 mutation
- MicroSatellite Instability (MSI) testing done through PCR
-- MMR deficient / MSI-high have better px per stage, dont respond well to 5-FU, and are better treated c irinotecan
- endometrial ca may be used c these stains possibly
*** Think of them in pairs, with the lower one getting messed up first: SH's go together; MLH and PMS go together; abnormality in MLH -> PMS abnormality, MLH1 -> MLH6 abnormality ***
Gardner's syndrome: FAP + osseous / soft-tissue tumors and retinal hyperplasia
Turcot's syndrome: FAP and malignant CNS tumors
Molecular pathogenesis (at least 2 pathways):
1) microsatellite instability (MSI) pathway (15%)
- DNA mismatch repair gene mutations; seen in sporadic cancers and HNPCC
-- mutations accumulate but there is no definite morphological correlate; must compare cancer to normal tissue for MSI study
- microsatellites are short tandem repeats (STRs) which are repeating DNA elements 1-6 bps in length that repeat 10-50 times, though cells usually have microsatellite mismatch repair (MMR) system to keep these repeats the right length
- mutL homolog 1 (hMLH1), postmeiotic segregation increased 2 (hPMS2), mutS homolog 2 (hMSH2) and mutS hololog 6 (hMSH6) are the genes that correct the errors
- tumors c MSI have intense lymphocytic infiltrate, mucinous or signet ring cell features, Crohn-like rxn, or medullary growth pattern
- tissue can be MSI-High (MSI-H), MSI-Low (MSI-L) or Microsatellite Stable (MSS); MSI-H > 2 loci > MSI-L > 0 loci = MSS
- tumor analysis can be through PCR or IHC
-- by IHC, loss of nuclear staining indicates loss of gene function
- MLH1 and MSH2 are the MC to have gene mutations
- MSI-H don't respond well to 5-FU, may respond better to irinotecan
- BRAF mutation analysis can be done to diff MLH-1 promoter methylation (sporadic in colon ca's) from MMR germline defect
-- MSI-H tumors c BRAFV600E mutations are MC sporadic
- invasive MSI tumors usually c peritumoral lymphocytic infiltrates
Resistance to EGFR monoclonal ab (eg cetuximab) found in tumors c specific mutations in BRAF or KRAS; in particular KRAS codons 12/13 mutations or BRAFV600E mutation
2) APC / B-catenin (chromosomal instability) pathway (85%)
Normal colon loses an APC gene at 5q21 ("first hit" can be germline or somatic, APC is a regulator of the B-catenin gene) --> APC gets "second hit" (causing dec intracellular adhesion and inc prolif) --> colon at risk then c K-RAS mutation (12p12) which causes unregulated intracellular signal transduction;
--> an adenoma then loses p53 (at 17p13) or LOH at 18q21 which causes COX2 overexpression and loss of other cancer suppressor genes and then leads to cancer with additional mutations and telomerase dysfunction
- tumors c BRAF or KRAS mutations are usually resistant to anti-EGFR therapy
- Right sided tumors (from midgut) more than 2x as likely to have MSI-H and KRAS sequence variations compared to left-sided tumors (from hindgut) [3]
Dx: must suspect c Fe-deficiency anemia in older pts. "Apple core" lesion on barium x-ray; CEA tumor marker
Px: - 20% have metastatic disease at presentation, <20% 5 year survival if metastatic [3]
-- probability of developing metastatic disease is <10% for stage I, 10-20% for stage II, 25-50% for stage III
-- in patients with stage III disease, complete surgical excision with negative margins and neoadjuvant chemo reduces risk of mets to 20-30%
- in 10-20% of pts, metastatic CRC can be treated with surgery and chemo, and can sometimes be cured, esp if localized to a single organ and if there are a small # of mets (termed resectable) [3]
- however, most mets (>80%) are not resectable, and most patients that have resection of mets are not cured
- Patients with MSI-H and MMR-D have a better px than patients with microsatellite stable or MMI proficient tumors because they respond to immunotherapy agents [3]
- without treatment, survival with metastatic CRC is typically 6-12 mo
- CEA levels are used to monitor for recurrence (NOT for primary detection)
Screening: if no risk factors, start at age 50 yo c FOBT every year + colonoscopy q 10 yrs (or sigmoidoscopy q 5 yrs)
- if CRC in 1st degree relative, start at 40 yo or 10 yrs younger than relative was dx'd; repeat q 3-5 yrs
- c HNPCC or 3 family members in 2 generation (1<50 yo), colonoscopy at 25 yo q 2-3 yrs
- previous polyp: scope q 3-5 yrs
- previous ca: scope at 1 and 3 yrs, then q 5 yrs
Treatment for unresectable metastatic colorectal ca [3]

Signet-ring cell carcinoma of the colon
- uncommon histologic subtype of colon carcinoma (less than 5%)
- infiltrative epithelioid neoplasm extending transmurally into pericolonic adipose tissue/mesentery. Tumor cells demonstrate variable architectural patterns, including broad sheets and nests streaming through muscle and fibroadipose tissue, as well as single cell infiltrative growth. Individual cells are characterized by dense, hyperchromatic nuclei that are often compressed and eccentrically displaced by conspicuous intracytoplasmic mucin, seen in association with extracellular mucin surrounding groups of cells. Occasional cells with more marked cytologic atypia can be seen, as well as rare multinucleated giant cells within the muscularis propria
- Signet-ring cell carcinoma of the colon is classified as a primary colorectal adenocarcinoma with greater than 50% signetring growth pattern
- important pattern to recognize due to its worse prognosis and often higher stage at presentation
- increased incidence of lymph node metastases, as compared to conventional colon adenocarcinomas

Colitis-assoc Dysplasia and Colon Carcinoma
Dysplasia in UC separated into low and HG, or "indefinite"
- generally similar to other sites, though LG-dysplasia is more difficult to dx c inflam present; and reqs dysplasia up to mucosal surface w/o loss of nuclear polarity
- HG has loss of nuclear polarity
- AMACR expression may be a specific marker for dysplasia (though reagents need to be titrated to different concentrations)
Dysplasia-associated lesion or Mass (DALM) is a polypoid lesion that is generally not well-defined and arises in inflamed areas of mucosa and should be treated c colectomy
- normal polyps that subsequently get surrounded by an inflam process are more well defined and polypectomy is sufficient tx
Colorectal adenocarcinoma
Dx usually not difficult, but can require clinical correlation
- invasive ca has angulated glands and single cells in a desmoplastic stroma; these are usually mod-diff and have necrotic debris in glands that are more well diff
-- can be problematic if only superficial bx is taken
-- if a large polyp is seen and only an in situ component is taken, may be reasonable to offer right-sided colectomy 2/2 difficulty of removing polyps from this region
-- if ca is seen, should report if adenoma is also seen, to ensure the lesion is primary and not a met
IHC: usually CK7 neg, CK20+, CDX2+, though MMR defects can alter this profile
Anal adenocarcinoma
Rare; need to exclude secondary involvement by colorectal ACa; grouped by etiology (see below)
- may arise ~10 years after fistula forms
Can show different morphologies and IHC staining patterns, based on their proposed etiologies
1) Anal gland adenocarcinomas (from anal glands)
- haphazarly dispersed glands + minimal mucin
- (+) CK7 and MUC5A, negative CK20 and CDX2
2) Fisula / Crohn's-associated
- mucninous carcinoma
- (+) CK20 and CDX2, -/+ CK7
3) Instestinal phenotype (ie resembles rectal adenocarcinoma)
- (+) CK20/CDX2, -/+ CK7
4) Adnexal / anogenital mammary-like glands
- (+) CK7 / hormone receptors / GCDFP15
Anal / colorectal carcinomas thought to be from firld effect of chronic inflammation, compared to conventional CRC, these tumors have
- early TP53 mutations
- increased c-MYC, HER2 / IDH1 mutations
- decreased KRAS mutations
Anal adenocarcinoma

Sarcomatoid Carcinoma
- aka spindle cell carcinoma
Rare but very aggressive subtype of colon adenoca, usually in elderly pts; usually a bulky tumor
- by definition is a biphasic tumor with both malignant epithelial and mesenchymal components
- clinically have rapid growth and early mets
Micro: epithelial component with abrupt transition to sarcomatous component and made of high grade spindle cells that can mimic other non-epithelial lesions
IHC: mesenchymal component retains keratin expression and thought to be dedifferentiated adenocarcinoma rather than true sarcoma
- negative: S100 (vs melanoma), Ckit and DOG1 (vs GIST), WT1/calretinin (vs mesothelioma)
- true sarcomas are keratin negative
Tx: surgery, chemo, close F/U
Histological findings of Sarcomatoid carcinoma (spindle cell carcinoma). (A) Diffuse proliferation of spindle-shaped cells with infiltration of neutrophils is seen (H&E, ×40). (B) Atypical spindle-shaped cells with nuclear enlargement and polymorphism are observed (H&E, ×400). Both vimentin (C) and cytokeratin (D) are positively stained on the same section (immunohistochemical stain, ×100).
Reference: https://synapse.koreamed.org/search.php?where=aview&id=10.4166/kjg.2013.62.2.126&code=0028KJG&vmode=PUBREADER

Carcinoid tumors /neuroendocrine tumors (NET)
Found incidentally in 1% of resected appendices
- assoc c acute appendicitis
- well-diff NETs mostly limited to rectum
Gross: 3/4 found at appendiceal tip
Tumor of endocrine (Kulchitsky) cells (APUDoma); MC site is small bowel (~50% of small bowel tumors ?
Small bowel tumors: ACLS ***
Adenoca (50%), Carcinoid (25%), Lymphomas (20%), Sarcomas
Dense-core bodies seen on EM
Sometimes makes 5-HT leading to carcinoid syndrome
- if tumor confined to GI, usually no carcinoid syndrome
-- must either spread to area past liver or overload liver c 5-HT to produce sx
Sx: wheezing, rt-sided heart murmurs, diarrhea, flushing
- may cause pellagra
Dx: 5-HIAA (5-Hydroxy-IndoleAcetic Acid) in urine
- may be able to stimulate tumor c pentagastrin
Classification based on Ki67 and mits, though staging based on size (see below)
- alternatively can be classified based on embryologic (fore/mid/hindgut) location [MC in midgut]
G1 - Low grade (well-differentiated [WDNT])
- 2 mits/10 hpf; <2% Ki67
- corresponds to carcinoid
G2 - Intermediate grade
- 2-20 mits/10 hpf; 3-20% Ki67
G3 - Neuroendocrine carcinoma / poorly-differentiated tumors
- can be small or large cell and have high mitotic rates and lots of necrosis; median survival is a little more than a year
Goblet cell carcinoid - is biphasic c neuroendocrine component and carcinoma component
- may present as appendicitis
- Px: aggressive compared to other appendiceal neuroendocrine tumors
Tubular carcinoid - B9, uncommon variant of well-differentiate neuroendocrine tumor of the appendix, usually in mucosa and submucosa
- made of small tubular proliferations with occasional trabeculae
- can have extracellular or intraluminal mucin, but not intracellular mucin
(+) CHR/SYN patchy or focal, CK7/20 noncontributory
Some lymph aggs may look like WDNT
IHC: chromogranin A, synaptophysin (~100%), CD56, PAP (in rectal?), focal AE1:AE3 (in NEC)
- negative PSA (also rectal?)
Tx: Octreotide (IV), and ondasetron (for diarrhea)
- cyproheptadine - anti-seratonin tx
- rt hemicolectomy if resection margin is positive
- ileocolectomy indicated if tumor present at resection margin, tumor extends to mesoappendix, tumor present in extra appendiceal lymphatics, tumor measures =2cm or evidence of mets
Px: Primarily related to tumor size (2 cm cutoff); then to depth of invasion
TX: The primary tumor cannot be evaluated.
T0: There is no evidence of cancer in the appendix.
T1: The tumor is 2 centimeters (cm) or smaller.
-- T1a: The tumor is 1 cm or smaller.
-- T1b: The tumor is larger than 1 cm but no larger than 2 cm.
T2: The tumor is larger than 2 cm but smaller than 4 cm, or it has extended into the large intestine.
T3: larger than 4 cm or has extended into the small intestine
T4: tumor directly invades the abdominal wall or other nearby organs.
- well-diff tumors pretty indolent, whereas poorly-diff are aggressive
- appendiceal carcinoids have the best px of all carcinoids despite the fact that perineural invasion is often identified; appendiceal carcinoids rarely give rise to distant mets
Carcinoid tumor (NET) of appendix

Nested rectal carcinoid tumor

Goblet cell carcinoid

Tubular carcinoid

Mucinous appendiceal neoplasms
Found in <2% of resected appendices
Gross: lots of mucin in lumen
- may present as pseudomyxoma peritonei (PMP), which is pools of mucin in fat or visceral serosal surfaces or can fill the abdominal cavity
- considered metastatic (M1a) if spreads beyond abdominal LRQ
Micro: Tumors cells c abundant cytoplasmic mucin c acentric, atypical nuclei
Tx: simple appendectomy if unruptured
- bulk resection c PMP
- systemic chemo c high-grade lesions
Px: low grade's 5-year survival is nearly 2x that of high-grade (63 vs 38%)
- finding extra-appendiceal mucin with low grade epithelium has the greatest risk of progression (finding acellular mucin or even high-grade epithelium confined to the appendix does not matter as much)
Mesenchymal tumors
Smooth Muscle Tumors
Leiomyomas look like bright red spindle lesions in muscularis mucosa and are managed c polypectomy
usually small and in distal colon
- (+) SMA and desmin; neg CD34, CD117 and S100
Leiomyosarcomas appear similar in colon as other places in body, c perpendicular fascicles of spindle cells c pleomorphic blunt-ended nuclei
GISTs are the MC spindly lesion of GI; 70 yo's, M>F, usually in distal colon and are transmural with bulging
- may be considered malig if >5 cm and >5 mits; skeinoid fibers indicate better px
(+) CD117, DOG1 (Ca2+-regulated Cl channel protein)
Ganglioneuromas
Can be solitary or syndromic and multiple
- solitary lesions have wide age range, M=F, usually left colon
- ganglioneuromatosis polyposis is assoc c FAP; and diffuse ganglioneuromatosis assoc c MENIIb
- appear as ganglion cells and spindled Schwann cells; can usually be dx'd w/o IHC, but are S100, SYN and NFP (+)
- neurofibromas do not have ganglion cells
Schwannomas
Lack capsules and have prominent lymphoid cuff
- diffuse strong S100 and neg CD117/c-kit
Benign Fibroblastic Polyps / Perineuromas
small, solitary, incidental polyps in distal colon
- bland, monomorphic spindle cells in concentric fashion around vessels and crypts; no mits or necrosis
- usually limited to mucosa, can go into submucosa
- (+) vimentin only; negative S100 CD31, CD117 and desmin; but can express a perineural marker (EMA, claudin-1, or GLUT-1); Ki67 is low (~1%)
Benign epithelial-stromal polyps with serrated epithelium are biologically simialr to sessile serrated polyps and should be classified as such to ensure proper clinical surveillance [4]
- the nature of polyps without serrated crypts is less clear, but evidence that they are perineuromas is circumstantial at best

Not a perineuroma?? Another mixed epithelial-stromal polyp contains a poorly circumscribed spindle cell proliferation that compresses and distorts tubular crypts. B, Plump spindle cells are arranged circumferentially around crypts, and fine tendrils of collagen are present in the intervening mucosa. C, Crypts at the edge of a polyp are surrounded by compact layers of spindle cells separated by lamina propria. D, Another lesion contains slightly dilated crypts and spindle cells with thin, tapering cytoplasmic processes associated with thin collagenous tendrils. [3]
Mucosal Schwann Cell Hamartoma
B9, intramucosal neural prolif that presents as polyps
Diffuse, ill-defined prolif of spindle cells in lamina propria surrounding colonic crypts
- consists purely of Schwann cells (diffuse S100 staining, vs patchy staining in neurofibromas)
- absent ulceration, atypia or mits
- (+) diffuse S100; neg CD34, GFAP, EMA, SMA, and CD117
- ddx is neurofibroma, which can appear similar, though neurofibromatosis is more pleomorphic and not as much S100(+); ganglioneuromas have more ganglion cells
Mucosal schwann cell hamartoma

Benign Epithelioid Nerve Sheath Tumor
Left colon of older pts, up to 1 cm; more rare than other tumors
- micro: have pseudoinclusions and made of spindle epithelioid cells in nests and whorls
- no mits
- (+) diffuse S100, neg melanoma markers, CD117, calretinin; CD34 variable
Granular Cell Tumor (GCT)
Rare, colon is 2nd MC location of GCT (after esophagus); similar appearance as other places; MC in whites; usually right colon
- can be infiltrative or well-defined and can lymphoid cuff and have cytologic atypia c calcs
- absent mits and necrosis
Lipoma
Rare; usually sporadic and in submucosa, but can be assoc c Cowden syndrome
Vascular Lesions
Bx of vascular ectasia can result in profuse bleeding
- Kaposi assoc c HIV (HHV8+)
- can also see hemangiomas, Dieulafoy lesions, lymphangiomas and vascular malformations; usually the diff is descriptive
- angiosarcomas are usually deeper and dx'd on resections
Hematopoietic tumors
Lymphomas MC In small bowel; most stuff in lg bowel are lymph aggs, and DLBCL is MC lymphoma in lg bowel (usually rt side)
- immunosuppressed esp at risk; endoscopically tumors are ulcerated, fungating, infiltrative
- DLBCLs are similar to those elsewhere
- FL is rare; tho if present are similar to elsewhere
- ENMZ can present as multiple polyps, most cases have sm and lg bowel involvement if in GI
- MCL can manifest as lymphomatous polyposis, non-specific
- Burkitt lymphoma presents at extranodal sites, such as GI tract
- mast cells (+) CD117, mastocytosis is a possibility
- Langerhan cell histiocytosis is rare in pts c systemic dz, (+) CD1a and S100
Rectum
Embryology
Forms during 4-7th WGA, the upper 2/3 coming from endoderm and the lower 1/3 coming from ectoderm, meeting at the pectinate line
Anatomy / Basics
Technically begins as rectum goes into puborectal sling (the butthole sphincter) and ends at squamous mucocutaneous junction
- upper 1/3 of rectum covered by peritoneum on front and both sides
- middle 1/3 covered by peritoneum only on anterior surface
- lower 1/3 has no peritoneal covering
Bx can have glandular, transitional or squamous mucosa

Anal anatomy [5]

Histology
Anal canal extends from the anal verge to the rectal mucosa, most of which is covered by squames
- dentate line is border which is visibly identifiable bwt distal squamous mucosa and transitional area of squamous and nonsquamous mucosa (which can have rectal glandular mucosa or transitional [urothelioid] mucosa)
- apocrine glands can be prominent and melanocytes can be found at the pectinate line
- anal canal also has mucus glands lined by stratified columnar epithelium
Anal ducts/glands. These are small tubules that tend to be surrounded by a cuff of lymphoplasmacytic cells akin to a lamina propria as in the colon. [5]`


Hemorrhoids
aka Dude's menstruation
Common, most likely 2/2 slippage of normal structures, and are normally found in subepithelial space of anal canal
• Probably affect about 5% of US persons, age 45 65 [5]
• Believed to be varicosities in the past but now believed to
reflect slippage of normal structures.
• Hemorrhoidal cushions are amazing they are a stopper and
allow anus to fully close, even allowing gas to remain inside
• Hemorrhoidal vessels are usually above the dentate line on
the left lateral, right anterior, and right posterior aspects of the
anal canal.
• Symptomatic hemorrhoids can be found above (internal) or
below (external) the dentate line.
External hemorrhoids. There is massive thrombosis and ulceration
of the overlying mucosa. [5]

Hemorrhoidectomy specimen. Large ectatic blood vessels are present, some stuffed with erythrocytes. This is an internal hemorrhoid sample because there is both colorectal type mucosa and squamous mucosa. It is important to study such samples carefully note the squamous findings indicated by the arrow! (bottom)


Anal fissures
• Common, sharp edged longitudinal skin defects
• Primary from damage to anal skin (hard stool, sexual penetration, chronic diarrhea)
• Secondary are from Crohn’s disease and infections
• They tend to become chronic from a lovely vicious cycle: Acute anal fissure pain anal spasm reduced blood flow/ischemia of anal skin incomplete healing chronic anal fissure.
Anal fissure with "sentinel tag" [5]


Anal fissure with sentinel tag (at upper left) [5]
Anal Fistula
• Often arise in anal transitional zone from small glands
• They can end blindly or have a secondary opening
• Secondary epithelialization establishes persistent fistulas the therapeutic goal is to obliterate epithelium in the tract by fistulotomy, fibrin glue injection, laser ablation, and fistulectomy (last resort).
• When operations are performed, surgeons sometimes inject ink into the tract

Anal fistula, primary opening it is at the junction of the squamous and transitional mucosa! [5]

This is the distal end of an anal fistula, which can be recognized by the overlying cornifying epidermis and a nearby hair follicle (arrow). Only one third of the fistula tract is lined by epithelium (the latter lacks a granular layer), two thirds are lined by granulation tissue. [5]
Pilonidal disease
Pilonidal disease with hair shafts and giant cells [5]

Chronic Perianal Dermatitis
• Also termed perianal dermatitis
• Allergic (wet wipes, fecal soiling)
Micro: Looks like contact dermatitis elsewhere
- Acanthosis
- Hypergranulosis
- Hyperkeratosis
- Eosinophils and lymphocytes
- Spongiosis
Chronic perianal dermatitis [5]


Papillary endothelial hyperplasia (vegetant intravascular hemangioendothelioma)
asdf
Hemorrhoidal vessel with papillary endothelial hyperplasia [5]


Infectious Proctitis
• Changing perceptions of HIV infection, its lethality, and the introduction of PrEP ( Pre exposure prophylaxis), now on the uptick [5]
• MSM taking PrEP are up to 44.6 times more likely to contract
syphilis infection than MSM populations who are not on PrEP
• MSM may feel it is irrelevant to disclose sexual orientation to GP
• 75% have never been asked
• Other barriers to testing; Subset of HIV primary care providers report:
• Lack testing and treatment knowledge
• Lack of time
• Discomfort with sexual history taking and genital examination
Herpes proctitis [5]
CMV proctitis

Radiation Proctitis
Can cause thickened vessetls

Don’t forget that radiation proctitis results in thickened
mucosal vessels [5]
Hirschsprung's disease
see above discussion in Colon...
Congenital megacolon caused by lack of ganglion cells / enteric nervous plexus
2/2 failure of neural crest cell migration (BOTH Meissners and Auerbach's plexus absent) from neural tube to ganglion cells of ENS
- rectum is always affected
Presents as chronic constipation early in life and usually failure to pass meconium (CF causes this also)
- risk factors: Down syndrome, Celiac dz, annular pancreas, duodenal atresia
Dx: Full-thickness bx shows aganglionic cells in submucosa
Tx: diverting colostomy
Irritable Bowel Syndrome (IBS)
Can present c diarrhea, constipation, or alternating stool patterns for > 3 mo
Pain improves c defectaion, change in stool frequency and consistency
- No structural abnormalities
Tx: inc fiber intake, hyocyamine / dicyclomine (anti-spasmodics)
Crohn disease involving anal canal [5]


Peri-anal / anal Crohn disease [5]
Crohn's Disease
• The anal canal is involved in ~25% of patients with small intestinal disease and 50 - 80% of those with colonic disease
• May be initial presentation of Crohn's disease in one third of patients
Ulcerative Colitis
see above
Inflammatory polyps
Inflamed mucosa that sticks out into lumen
Inflammatory Cloacogenic Polyps
• Manifestation of mucosal prolapse syndrome in the anal canal
• Mucosal prolapse → local trauma and ischemic injury → inflammation, repair and regenerative changes
• Slight female predominance
• Occurs at any age; but 80% under 50 years.
• Less common in cultures with high dietary fiber content
• Typical presentation rectal bleeding of long duration
• Most common location is anterior wall of anorectal junction
• Chronic disorder, requiring conservative approach to manage patient discomfort
• Medical therapy includes increase in dietary fiber or topical treatment with human fibrin sealant
• Frequently recurs after therapy
• Typically sessile
• May be single or multiple
• Usual size 1 2 cm
• May mimic tubular adenomas



Pseudopolyps
Bumps of regenerating mucosa that stick out into lumen and are composed of normal colonic mucosa that can form mucosal bridges bwt other pseudopolyps
- coexist c inflammatory polyps
Filiform (postinflammatory) polyps
Rare form of polyposis c long, thin polyps
- giant filiform polyposis: when lots of single filiform polyps coalesce into a mass
May be result of inflammatory process
Can cause obstruction requiring surgery, but not bad in and of themselves
Hidradenoma Papilliferum
b9, cystic and papillary apocrine tumor in vulva and perianal skin
- usually in white F > 30 yo
- rarely malig
- Typically seen as small (2 3 mm) dermal nodule covered by unremarkable skin
- asymptomatic
Micro: big cyst lined by epithelium in middermis c complex papillary folds c fibrovasc cores lined by 2-layered cuboidal epithelium c bridging and tufting
- Lesion unencapsulated, but well circumscribed
- no inflam, most superficial portion can have flat sq epithelium
IHC: (+) mesothelial markers, CK5/6, ER
Tx: resection is curative

hidradenoma papilliferum



Hypertrophied anal papilla
Hypertrophied anal papilla versus anal skin tags
• Used interchangeably by many but they differ
• Hypertrophied papillae are at the dentate line and you need an anoscope to see them
• Skin tags are at the anal verge so you can see them without doing a procedure and they “hang off” hemorrhoids, fissures.
Enlarged anal papillae [5]


Enlarged anal papillae no granular layer, myxoid stroma [5]
Anal papilla with striking stromal reactive
changes [5]

Anal tag
adsf
Anal tag [5]


Anal tag surface has a granular and is
keratinized [5]
Papillary immature squamous metaplasia
• Looks like HSIL on a peek; biologically less horrible than LSIL
• But no mitotic activity; negative p16
Papillary immature squamous metaplasia

Condyloma acuminata
• Condylomas go in the LSIL group but are special since they do not
always show dysplasia
• The overwhelming majority of condylomata acuminata is and will remain benign. They are subsumed in the LSIL group only by virtue of their ability to develop dysplasia/intraepithelial neoplasia and invasive carcinoma (which, however, is a rare phenomenon).
• HPV driven
• Tiny nothing lesions to large plaques
• •>200 HPV types known, divided into low and high risk
• Over 90% of condylomas are low risk
• Left in place frequently tend to have secondary changes when excised







Condyloma - it’s outside - see the skin appendage?
Condyloma with dainty koilocytes but not really dysplastic
Condyloma with nonspecific inflammation
Condyloma acuminatum. This example shows low grade
dysplasia (intraepithelial neoplasia). The correct designation
according to LAST project criteria is: LSIL (condyloma, PaIN 1).
Condyloma acuminatum. Moderate dysplasia is present. The inset shows an abnormal mitosis. Designation: HSIL (condyloma, PaIN2).
Condyloma acuminatum. High grade dysplasia with nearly full thickness alterations of the epithelium and overlying hyperparakeratosis; HSIL (condyloma, PaIN3).
Higher magnification of the prior image
1 - 7
<
>
Anal Intraepithelial Neoplasia (AIN)
Risk factors: HPV, heavy smoking, HIV, radiation, immunosuppression
- invasive anal ca is aggressive
- histo is similar to that seen in uterine cervix
- basically have dark pleomorphic nuclei and loss of polarity and nuclear stratification,
- HPV viral cytopathic changes seen in flat and exophytic lesions
- dysplasia extending into colonic glands should not be mistaken for neoplasia
- if it has dense dermal / lamina propria fibrosis and lots of plasma cells, may be 2/2 syphilis (syphilis proctitis)
- "Bowen disease" is term of SCIS at anal margin, that looks like a brown papile
Classification:
AIN 1: mild dysplasia
- mits and dysmaturation confined to bottom 1/3 of epithelium
- assoc c HPV 6
AIN 2: moderate dysplasia
AIN 3: severe dysplasia
- mits and dysplasia throughout entire epithelium
- assoc c HPV 16 (higher number for higher grade)
- DNA methylation of IGSF4 and DAPK1 specific for AIN 3 and SCC
IHC: strong diffuse p16 and >50% Ki67 are most helpful, reduces intraobserver variability
- p16 is the best as inc Ki67 can be seen in some reactive conditions
IHC: Using P16 and Ki67 [5]
• Ki 67, is a sensitive and specific marker for dysplasia in mature squamous epithelium and is therefore helpful for confirmation of AIN1 and condyloma.
• A Ki 67 positive result can be defined as the presence of a cluster of at least two strongly stained epithelial nuclei in the upper two thirds of the epithelial thickness.
• This labeling pattern does NOT separate low and high grade intra
epithelial neoplasia.
• Additionally, it does not separate low risk from high risk HPV type lesions.
• LASTly, it does not distinguish reparative changes from intra epithelial neoplasia.
• Based on the limitations of Ki 67 labeling, it is useful to combine it with p16 immunolabeling, which is evaluated using a two tier system:
1. Absent or discontinuous, patchy nuclear and cytoplasmic staining
pattern is considered as a negative result.
2. A positive result consists of diffuse and strong staining of cells of the
basal and parabasal layers of the squamous epithelium, with or
without superficial staining.
DDx: neuroendocrine tumor may mimic AIN
Tx: electrofulguration, infrared coagulation, immunomodulation tx c imiquimod 5% cream and surgery
AIN 3

Anal transitional mucosa (left), and HSIL.AIN2-3 (right) same magnification [5]

High grade anal intraepithelial neoplasia. This lesion is very subtle on hematoxylin and eosin but several atypical mitoses are a clue that this is a high grade lesion. [5]

Anal Squamous cell Carcinoma (ASC)
80% of anal tumors, ~1% of digestive system cancers; Margin cancer (anal verge to 5 cm on perineal skin); canal cancer (proximal to anal verge to internal sphincter)
- was thought to be caused by Crohn dz and tx'd c abdominoperineal resection, now assoc c HPV/STDs and given rads/chemo
- dubbed Bowen's disease when in situ (Bowen's Squamous [BS])
- if occur distal to dentate are keratinizing, if proximal to dentate are non-Keratinizing (previously known as cloacogenic or transitional cell; now broken down morphologically into large or small cell)
-- bladder and anus have shared embryologic origin
- inc risk of anal ca c condylomata, but not hemorrhoids, fistulae or fissures or inflam bowel dz
- women c hx of herpes of Chlamydia at inc risk
- smoking also inc risk
An important variant worth distinguishing...
Verrucous carcinoma can have broadbased sq papillae in a sheet-like sclerotic background
- usually have strange keratinization pattern and lots of neuts
- lack FV cores
- tx is local excision which can be difficult 2/2 size
- px: mets rare
Early invasion (superficially invasive SCC)
• Depth 3 mm
• Width 7 mm
• Even with vascular space invasion, good outcome
Lymphatic drainage pathway depends on tumor location
- above dentate flows to perirectal and paravertebral nodes
- below dentate through inguinal and femoral nodes
DDx: reparative pseudoepitheliomatous hyperplasia 2/2 other dz process (can be profound and have squamous pearls)
- also ddx Paget dz or mets (melanoma, urothelial ca [neg HPV ish], neuroendocrine small cell ca)
• Basal cell carcinoma can be peri anal despite the lack
of sun exposure (Can be a diagnostic pitfall) --> Immunostaining can help (negative p16, very positive BEREP4 (EpCam)
Tx: Nigro protocol: Chemoradiation then bx
Px: 6/10 alive at 5 yrs; most dependent on size, node status and mets
- 4/5 cured if <2 cm, <1/2 if > 5 cm
- keratinized vs non-K does not affect px
early invasive SCC (depth <3 mm, width <7 mm) [5]

Verrucous carcinoma (giant condyloma of Buschke L wenstein). A large cauliflower like mass emanates from the anus, peri anus and perineum image courtesy of G. Weyandt, Bayreuth [5]

Basal cell carcinoma
Can be peri anal despite the lack of sun exposure (Can be a diagnostic pitfall)
IHC: negative p16, very positive BEREP4 (EpCam)
Basal cell carcinoma [5]

BerEP4

CYLD mutant Cylindroma like Basaloid Carcinoma of the Anus
CYLD mutations, seen in cases of familial and sporadic cutaneous cylindroma, are found in about 10 15 of anal carcinomas
• Anal carcinomas with CYLD mutations are enriched for younger patients, women, and near universal infection with HR HPV, mainly HPV 16
• Basaloid neoplastic cells surrounded by a thick basement membrane arranged in a jigsaw pattern and displaying hyaline globular inclusions
• CYLD mutations have been identified in about 20 of head and neck carcinomas associated with cylindroma like histologic
features
Reference
Williams EA, Montesion M, Sharaf R, Corines J, Patel PJ, Gillespie BJ, et al CYLD mutant cylindroma like basaloid
carcinoma of the anus a genetically and morphologically distinct class of HPV related anal carcinoma Mod Pathol 2020
12 33 12 2614 25
CYLD mutant cylindroma like basaloid carcinoma of the anus [5]

p16

Paget's disease of the anus
MC in elderly; found in apocrine gland-rich sites such as perianal zone
- commonly presents c pruritis
- can be assoc c synchromatous or metachronous ca of rectum
- slow growing red plaque like eczema
Gross: Raised, erythematous lesion in anal canal / perianal skin
Micro: Large pale cells infiltrating c vacuolated cytoplasm in small clusters or individually
- vacuoles are comprised of mucin (therefore PAS / alcian blue-[+])
DDx: pagetoid Bowen's disease, melanoma
IHC: (+) CEA, EMA,CAM5.2, CK7, CK20, GCDFP (var?)
-
- if assoc c colorectal adenoca are GCDFP and CK20 (if MSI) neg
Tx: Wide excision
- if assoc c underlying adenoca, tx assoc c that
Px: Recurs and can be locally invasive
Anal Adenocarcinoma (AC)
Anal adenocarcinoma is a rare primary malignancy of the anus. While somewhat understudied, several categories and histologic subtypes have been proposed.
- slight male predominance and usually occurs in patients in their 50s
- Risk factors include HIV, Crohn’s disease, and smoking.
World Health Organization (WHO) categorizes primary anal adenocarcinomas into mucosal and extramucosal types.
- Most mucosal lesions are very similar to rectal adenocarcinomas and must be distinguished from spread of a rectal primary.
Rectal adenocarcinoma has an intestinal appearance histologically, with an intestinal immunophenotype (positive for CK20 and CDX2, negative for CK7).
-- Recently described HPV-associated anal adenocarcinomas are predominantly mucosal-based and therefore likely fit into this category. They usually show villous or papillary architecture and are strongly positive for p16 and CK7, with weak CDX2 expression. CK20 is generally negative.
Extramucosal anal adenocarcinomas are more complex, with three types included in the WHO classification.
1) anal gland adenocarcinoma (The term “anal duct adenocarcinoma” is discouraged.) These cancers arise in anal glands/ducts and therefore do not originate from a mucosal precursor. They can have a somewhat unique morphology, with rounded nuclei, amphophilic cytoplasm, and anastomosing glands. Cribriforming architecture and scattered, dispersed glands have also been reported.
2) Fistula-associated extramucosal anal adenocarcinomas arise in the setting of a longstanding fistula, often in patients with Crohn’s disease. They classically have prominent mucinous/colloid morphology, with pools of mucin and strips or clusters of malignant cells floating in and lining the pools. The morphology and immunophenotype may be rectal or anal.
3) extramucosal anal adenocarcinomas that do not fit into the “anal gland” or “fistula-associated” types are simply dubbed non-anal gland, non-fistula-associated. These are currently poorly defined.
Micro: pencillate nuclei, lots of necrosis, assoc c adenoma
- some can be mucinous (esp if assoc c fistula tract, which are usually unexpected findings)
DDx: prolapse polyps (inflam cloacogenic polyps) c prominent colitis cystica profunda (have diamond-shaped glands, fibromuscular mucosal stranding and bland cytology)
Genes: Molecular data are limited, but KRAS mutations are common.
Px: largely stage-dependent and is worse than for anal squamous cell carcinoma, which is much more common.
Angiokeratoma
Can be hemorrhagic and painful; 5 clinical forms
1- angiokeratoma corpus diffusum - generalized systemic form assoc c Fabry dz (B-galactosidase def)
2- Milbelli type - found over bony surfaces in teen's hands and feet
3- Fordyce type - usually in scrotum, but can affect perineum
4 - angiokeratoma circumscriptum - congenital, in LE
5 - solitary and multiple types in 10-30 yo's
Micro: dilated vessels, in upper dermis, bordered by rete ridges
- overlying epidermis can get hyperkeratotic and sometimes papillomatous that can look like warts clinically
- considered a form of telangiectasia (not really cancer)
Rectal angiokeratoma. Note the dilated vascular spaces present within the squamous epithelium

Mesenchymal tumors
Granular cell tumor
usually in esophagus, then colon and anus
- usually present as a nodule at anocutaneous junction
- abundant pink granular cytoplasm; (+) S100, CD68 and calretinin
GIST
Rare in anus, leiomyomas are more likely
Melanoma
Melanocytes are normal in anal canal and anal verge
- melanoma usually in white adults, presenting c mass and rectal bleeding
- can be sessile or polypoid
- px: poor outcomes
Polyps
Inflammatory Cloacogenic Polyp
Mucosal prolapse polyp in anorectal transition c sq and columnar mucosa
- presents c hematochezia, on ant wall of anal canal
- basically anal form of solitary rectal ulcer
Micro: tubulovillous growth pattern c surface ulceration, displaced clusters of crypts to submucosa and lots of fibrovascular stroma going to mucosa
Fibroepithelial Polyp (FEP)
aka anal tags (are basically acrochordons); usually not removed unless bothersome (can be painful)
- called a sentinel tag if occurs at the edge of an anal ulcer
- do not have the thrombi or hemorrhage
Micro: myxoid or collagenous stroma covered by squamous epithelium and most have stromal cells c 2+ nuclei
- bigger lesions usually have more atypical stromal cells
- freq mast cells
- subspithelial tissue c bizarre MNGCs and mast cell infiltrates
- surface changes can resemble viral effects, except in FEP the nuclei are small and uniform
IHC: (+) CD34, vimentin, desmin (var)
EM: fibroblastic and myofibroblastic features
References.
1. Histology from Protein Atlas. https://www.proteinatlas.org/learn/dictionary/normal
2. Hornick J. Polyps of the Large Intestine. https://clinicalgate.com/polyps-of-the-large-intestine/ Chapter 22
3. Biller L. Diagnosis and Treatment of Metastatic Colorectal Cancer: a review. JAMA2021;325(7):669-685
4. Hissong E. Epithelial-Stromal Polyps of the Colon Are Not Perineuromas. Am J Clin Pathol. July 2021; 156: 109-116
5. LASOP meeting January 2022.
